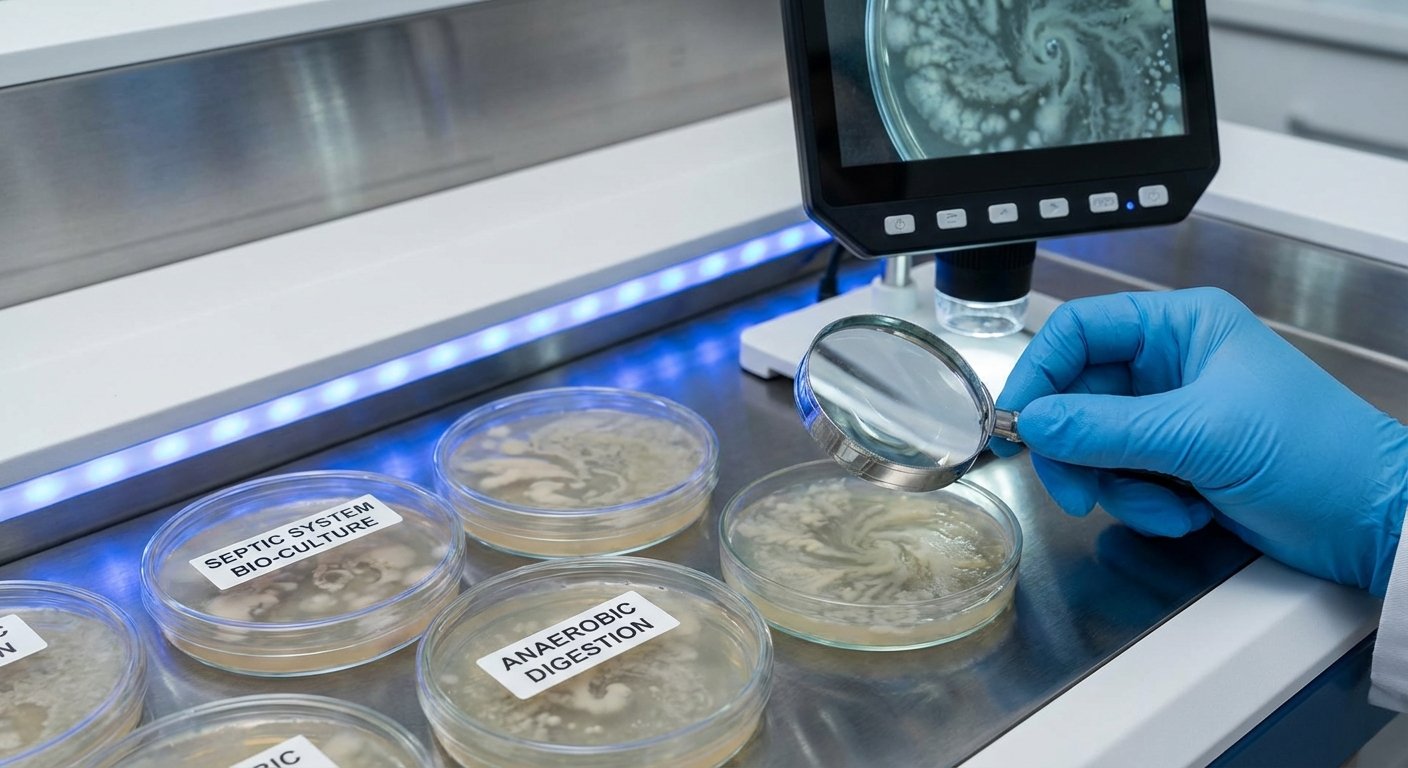
Baktēriju aktivitāte septiskā tvertnē notekūdeņu sadalē

Kā septiskās tvertnes baktērijas sadala notekūdeņus un samazina smaku?
Septiskās tvertnes baktērijas kā tās sadala notekūdeņus un samazina smaku ir būtiskas efektīvai notekūdeņu apstrādei un vides aizsardzībai.
Šajā rakstā atklāsim, kā mikroorganismi septiskajās tvertnēs veicina organisko vielu sadalīšanu un to, kā pareiza baktēriju apkope var palīdzēt saglabāt tīru vidi bez nepatīkamām smakas problēmām.
Uzzināsim, kā nodrošināt baktēriju līdzsvaru un kā izvairīties no biežāk pieļautajām kļūdām septiskās tvertnes uzturēšanā.
Kas ir septiskās tvertnes baktērijas?
Septiskās tvertnes baktērijas ir dabīgi mikroorganismi, kas dzīvo notekūdeņu tvertnēs un palīdz noārdīt organiskās vielas, tādējādi attīrot ūdeni un samazinot piesārņojumu.
- Anaerobo un aerobo baktēriju loma: Anaerobās baktērijas darbojas bez skābekļa, sadalot organiskās vielas, kamēr aerobo baktērijas palīdz papildus attīrīšanā, izmantojot skābekli.
- Dabiski sastopamie mikroorganismi tvertnē: Šīs baktērijas savstarpēji sadarbojas, veidojot ekosistēmu, kas nodrošina notekūdeņu efektīvu pārstrādi.
- Kāpēc tās ir būtiskas notekūdeņu attīrīšanai: Bez baktērijām netiktu veikta atbilstoša sadalīšanās, radot vides piesārņojumu un smaku problēmas.


Organisko vielu sadalīšanas process
Septiskās tvertnes baktērijas sadala notekūdeņus, palīdzot efektīvi sašķelt cietās bioloģiskās daļiņas un atvieglot notekūdeņu attīrīšanu.
- Kā baktērijas sašķeļ cietās daļiņas: Tās izdala fermentus, kas noārda organiskās vielas līdz vienkāršākām formām.
- Dūņu un peldošā slāņa veidošanās paskaidrojums: Procesa gaitā rodas dūņas un peldošās vielas, kas ir baktēriju un atkritumu miksa rezultāts.
- Fermentu nozīme sadalīšanās paātrināšanā: Fermenti paātrina organisko vielu šķelšanos, tādējādi uzlabojot tvertnes efektivitāti un samazinot smaku rašanos.

Kāpēc septiskajā tvertnē rodas nepatīkama smaka?
Ne patīkama smaka rodas, pateicoties konkrētiem ķīmiskiem savienojumiem un baktēriju līdzsvara trūkumam.
- Galvenie smaku izraisošie ķīmiskie savienojumi: Sulfīda un amonjaka savienojumi, kas veidojas, noārdoties organiskajām vielām.
- Kā baktēriju līdzsvara trūkums veicina smaku: Ja anaerobās un aerobās baktērijas nav sabalansētas, smaka var pastiprināties.
- Praktiski padomi smakas kontrolei un novēršanai: Regulāra tvertnes apkope un baktēriju papildināšana palīdz mazināt smaku intensitāti.
Kad un kāpēc nepieciešams pievienot baktērijas papildus?
Baktērijas papildus jāievada, ja sistēma ir cietusi no ķīmiskām ietekmēm vai pēc pārslodzes.
- Sadzīves ķīmijas ietekme uz baktēriju koloniju: Dezinfekcijas līdzekļi bieži iznīcina dabiskās baktērijas.
- Sistēmas atjaunošana pēc tīrīšanas vai pārslodzes: Papildu preparāti palīdz ātri atjaunot baktēriju līdzsvaru septiskajā tvertnē.
- Pareiza preparātu izvēle un lietošanas biežums: Izvēlieties kvalitatīvus baktēriju preparātus un ievērojiet ieteicamo lietošanas režīmu.
Kā pareizi uzturēt baktēriju līdzsvaru sistēmā?
Pareiza septiskās tvertnes uzturēšana prasa regulāru kontroli, izvairīšanos no kaitīgu ķīmisko vielu lietošanas un nepieciešamības gadījumā baktēriju papildināšanu. Tas nodrošina efektīvu notekūdeņu sadalīšanu un samazina nepatīkamu smaku rašanos.
Lai iegūtu speciālistu ieteikumus un kvalitatīvus baktēriju preparātus, apmeklējiet SepticMix veikalu vai sazinieties ar speciālistiem.
DUK
Kā septiskās tvertnes baktērijas palīdz samazināt smaku?
Baktērijas sadala organiskās vielas, novēršot to pūšanas procesu, kas rada nepatīkamu smaku. Tādējādi baktērijas nodrošina dabisku smaku mazināšanu.
Kāpēc ir svarīgi uzturēt aerobo un anaerobo baktēriju līdzsvaru?
Aerobo un anaerobo baktēriju līdzsvars nodrošina efektīvu un pilnīgu notekūdeņu sadalīšanu, kā arī samazina smaku rašanās risku.
Vairāk par notekūdeņu sastāvu un apstrādi varat uzzināt arī Šeit Wikipedia.

